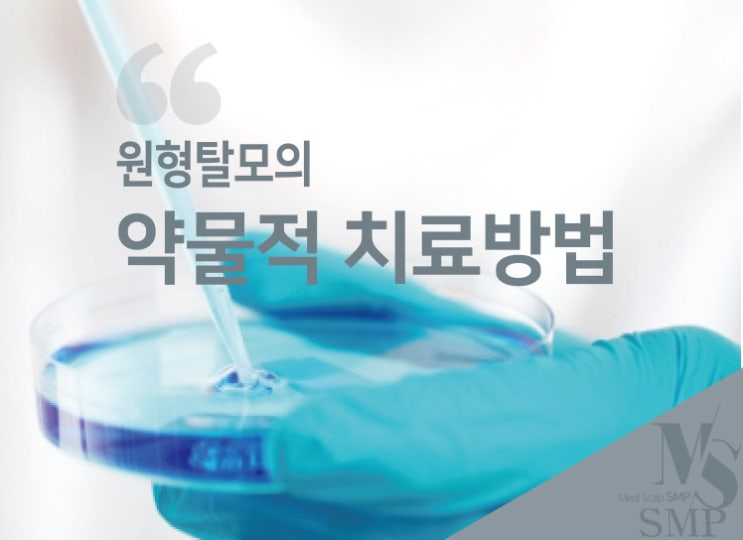

일상생활 속에서 틈틈이 하는 탈모관리
2025.02.24

탈모관리 어떻게 하고 계신가요? 탈모로 고민이 많지만 바쁜 일상생활로 탈모관리를 하기가 쉽지 않습니다....
출처
https://blog.naver.com/ppory0124/223334806389
이슈모어 핫이슈
-
 현아, 논란 대신 음악을 택했다… ‘못(Mrs. Nail)’로 드러난 현재형 선택
돌아온 현아, 논란 대신 음악으로 증명한 현재형 존재감 현아가 다시 음악으로 자신의 현재를 증명하고 있다. …
현아, 논란 대신 음악을 택했다… ‘못(Mrs. Nail)’로 드러난 현재형 선택
돌아온 현아, 논란 대신 음악으로 증명한 현재형 존재감 현아가 다시 음악으로 자신의 현재를 증명하고 있다. …
-
 조용히 돌아온 조병규, 영화 ‘보이’로 다시 증명한 존재감
조병규가 다시 스크린 앞에 섰다. 한동안 작품 활동에서 거리를 두었던 그는 최근 개봉한 영화 ‘보이’를 통해…
조용히 돌아온 조병규, 영화 ‘보이’로 다시 증명한 존재감
조병규가 다시 스크린 앞에 섰다. 한동안 작품 활동에서 거리를 두었던 그는 최근 개봉한 영화 ‘보이’를 통해…
-
 모모랜드 낸시, 무대 밖에서도 시선 집중…글로벌 행보와 ‘화이트 스프링’의 현재
모모랜드 낸시가 다시 한 번 주목받고 있다. 그룹 활동, 글로벌 프로젝트, 그리고 음악과 연기를 오가는 행보…
모모랜드 낸시, 무대 밖에서도 시선 집중…글로벌 행보와 ‘화이트 스프링’의 현재
모모랜드 낸시가 다시 한 번 주목받고 있다. 그룹 활동, 글로벌 프로젝트, 그리고 음악과 연기를 오가는 행보…
관련 포스팅
Copyright blog.dowoo.me All right reserved.